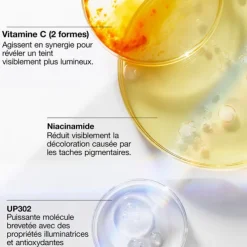
Even Better Clinical™

Even Better Clinical™
€51.52 Original price was: €51.52.€37.71Current price is: €37.71.
Développé par des dermatologues, ce nouveau sérum réduit visiblement l’apparence des taches pigmentaires et illumine la peau grâce à la molécule brevetée UP302, de la vitamine C et de la niacinamide pure.
Sa formule avancée enrichie d’acide salicylique et de glucosamine exfolie délicatement la peau pour accélérer le renouvellement cellulaire et révéler un teint plus uniforme. La formule est également enrichie d’ingrédients apaisants pour réduire les irritations cutanées pouvant entrainer l’apparition de nouvelles taches. Sa texture légère sans corps gras pénètre rapidement sans laisser de fini collant. La peau est visiblement plus lumineuse et les taches pigmentaires causées par le soleil, le vieillissement cutané ou les imperfections sont visiblement réduites.
Des ingrédients anti-taches puissants :
Vitamine C : deux formes de vitamine C qui agissent en synergie pour révéler un teint visiblement plus lumineux.
UP302 : une puissante molécule brevetée qui imite les propriétés illuminatrices et antioxydantes de la daniella ensifolia.
Niacinamide pure : réduit visiblement la décoloration causée par les taches pigmentaires.
Soumis à des tests d’allergie. 100% sans parfum. Développé et testé par des dermatologues. Testé ophtalmologiquement. Convient à tous les types de peau, même les plus sensibles. Non comédogène.
Bénéfices :
Réduit l’apparence des taches brunes.
Aide à prévenir les futures taches pigmentaires.
Exfolie en douceur la peauIllumine la peau.
96% montrent une réduction visible des taches pigmentaires dues au soleil et au vieillissement cutané sur les teints clairs*.
100% montrent une réduction visible de l’hyperpigmentation post-inflammatoire sur les teints plus foncés**.
94% déclarent que la peau paraît plus lumineuse, plus éclatante***.
*Test clinique sur 55 femmes après 8 semaines d’utilisation.
** Test clinique sur 34 femmes après 8 semaines d’utilisation.
***Test clinique sur 542 femmes après 4 semaines d’utilisation.
Appliquer deux fois par jour, matin et soir, sur l’ensemble du visage et du cou, en évitant le contour des yeux. Une ou deux doses suffisent.
Poursuivre avec une crème hydratante.
L’utilisation quotidienne d’un écran solaire est indispensable pour des résultats optimaux.
Les listes d’ingrédients entrant dans la composition des produits de notre marque sont régulièrement mises à jour. Avant d’utiliser un produit de notre marque, vous êtes invités à lire la liste d’ingrédients figurant sur son emballage afin de vous assurer que les ingrédients sont adaptés à votre utilisation personnelle.
WaterAquaEau, Dimethicone, Isododecane, Yeast ExtractFaexExtrait De Levure, Butylene Glycol, Polysilicone-11, Niacinamide, Ascorbyl Glucoside, Peg-10 Dimethicone, Peg-6, Acetyl Glucosamine, Glycerin, Sodium Hyaluronate, Squalane, Cholesterol, Helianthus Annuus (Sunflower) Seed Extract, Trametes Versicolor Extract, Glycyrrhiza Glabra (Licorice) Root Extract, Hordeum Vulgare ExtractExtrait D’Orge, Oryza Sativa (Rice) Bran Extract, Triticum Vulgare (Wheat) Germ Extract, Cucumis Sativus (Cucumber) Fruit Extract, Camellia Sinensis Leaf Extract, Caffeine, Salicylic Acid, Isohexadecane, Propylene Glycol Dicaprate, Glycyrrhetinic Acid, Dimethoxytolyl Propylresorcinol, Caprylyl Glycol, Stearamidopropyl Dimethylamine, Phosphatidylcholine, Sorbitan Oleate, Polysorbate 20, Polysorbate 80, Stearic Acid, Hexylene Glycol, Tromethamine, Citric Acid, Acrylamide/Sodium Acryloyldimethyltaurate Copolymer, Ammonium Acryloyldimethyltaurate/Vp Copolymer, Tocopheryl Acetate, Magnesium Ascorbyl Phosphate, Bht, Sodium Citrate, Disodium Edta, Nylon-12, Phenoxyethanol [ILN52877]
| Size | 30 ml, 50 ml |
|---|
Be the first to review “Even Better Clinical™” Annuler la réponse
Related products
Démaquillant & Nettoyant
Démaquillant & Nettoyant
Coffrets Femme
Démaquillant & Nettoyant
Lotion & Tonique
Eau De Parfum
Coffrets Femme
Gommage & Peeling
Démaquillant & Nettoyant
Démaquillant & Nettoyant
Démaquillant & Nettoyant
Eau De Toilette
Lotion & Tonique
Crème De Jour
Gommage & Peeling
Démaquillant & Nettoyant

Reviews
There are no reviews yet.